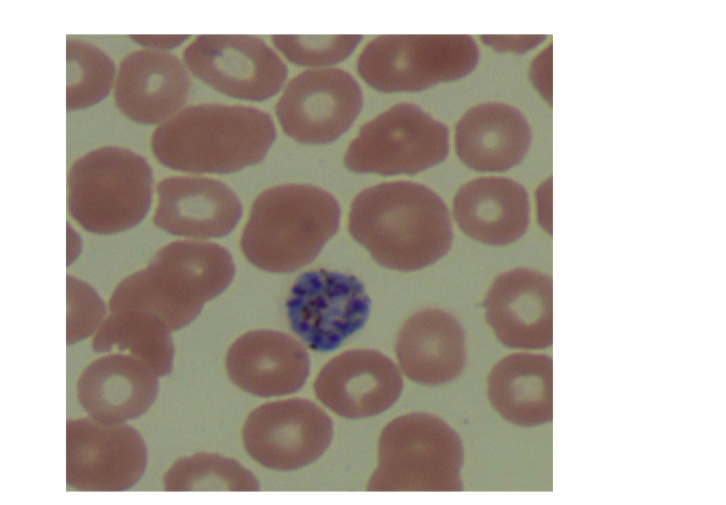
term image
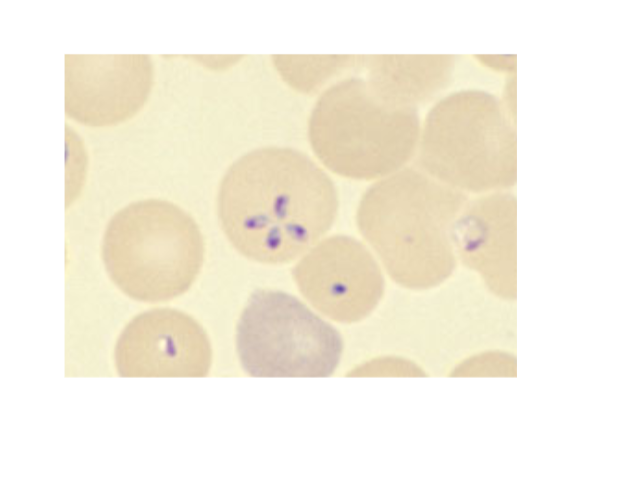
term image
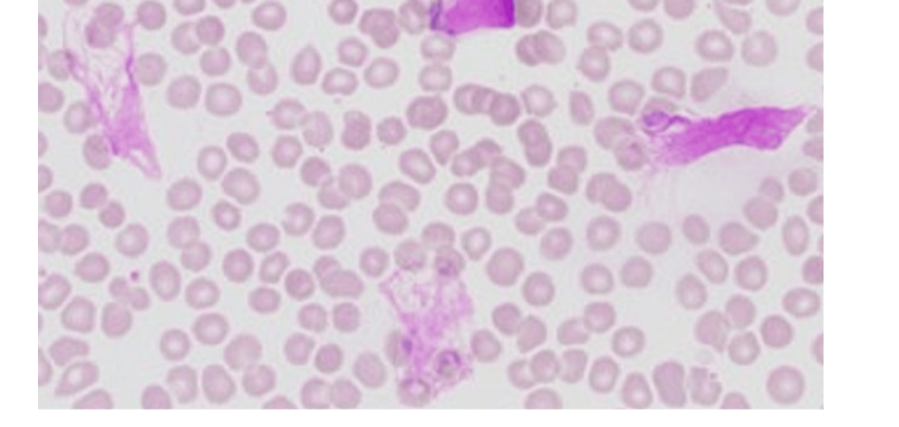
term image

Hematology Lab Week 9
1/10
There's no tags or description
Looks like no tags are added yet.
Name | Mastery | Learn | Test | Matching | Spaced |
|---|
No study sessions yet.
11 Terms
A previously healthy 35-year-old female complains of loss-of-appetite, vomiting, fever in irregular cycles and headaches.
Recent travel history revealed that she traveled to the WHO African Region.
See below for the blood count results, an image of the peripheral blood smear and the BinaxNow quick test result.
malaria
A previously healthy 60-year-old female complains of headache, muscle ache, joint pain, nausea.
No recent travel history, but the patient mentioned that they had a tick removed a couple of weeks ago.
See below for the blood count results and an image of the peripheral blood smear.
babesia
Mr. S, 65, reports feeling increasingly tired over the past few months. He has noticed occasional dark stools but
denies visible blood in the stool. He reports no significant abdominal pain, nausea, vomiting, or changes in bowel
habits.
colon cancer
You are a successful physician with your own practice. A young female has just entered your office. She has red, blotchy skin,
and the lymph nodes on her neck appear to be swollen. Just by looking at her, you suspect mononucleosis, but some information
is missing.
What kinds of questions would you ask her to rule out other infections?
What kinds of tests would you order to examine her?
Which test results would point toward mononucleosis?
-did you travel anywhere
-nausea, change of appetite
rapid step throat test, CBC, Monospot

fungus

bacterium

bacterium

fungi
parasite
parasite
parasite